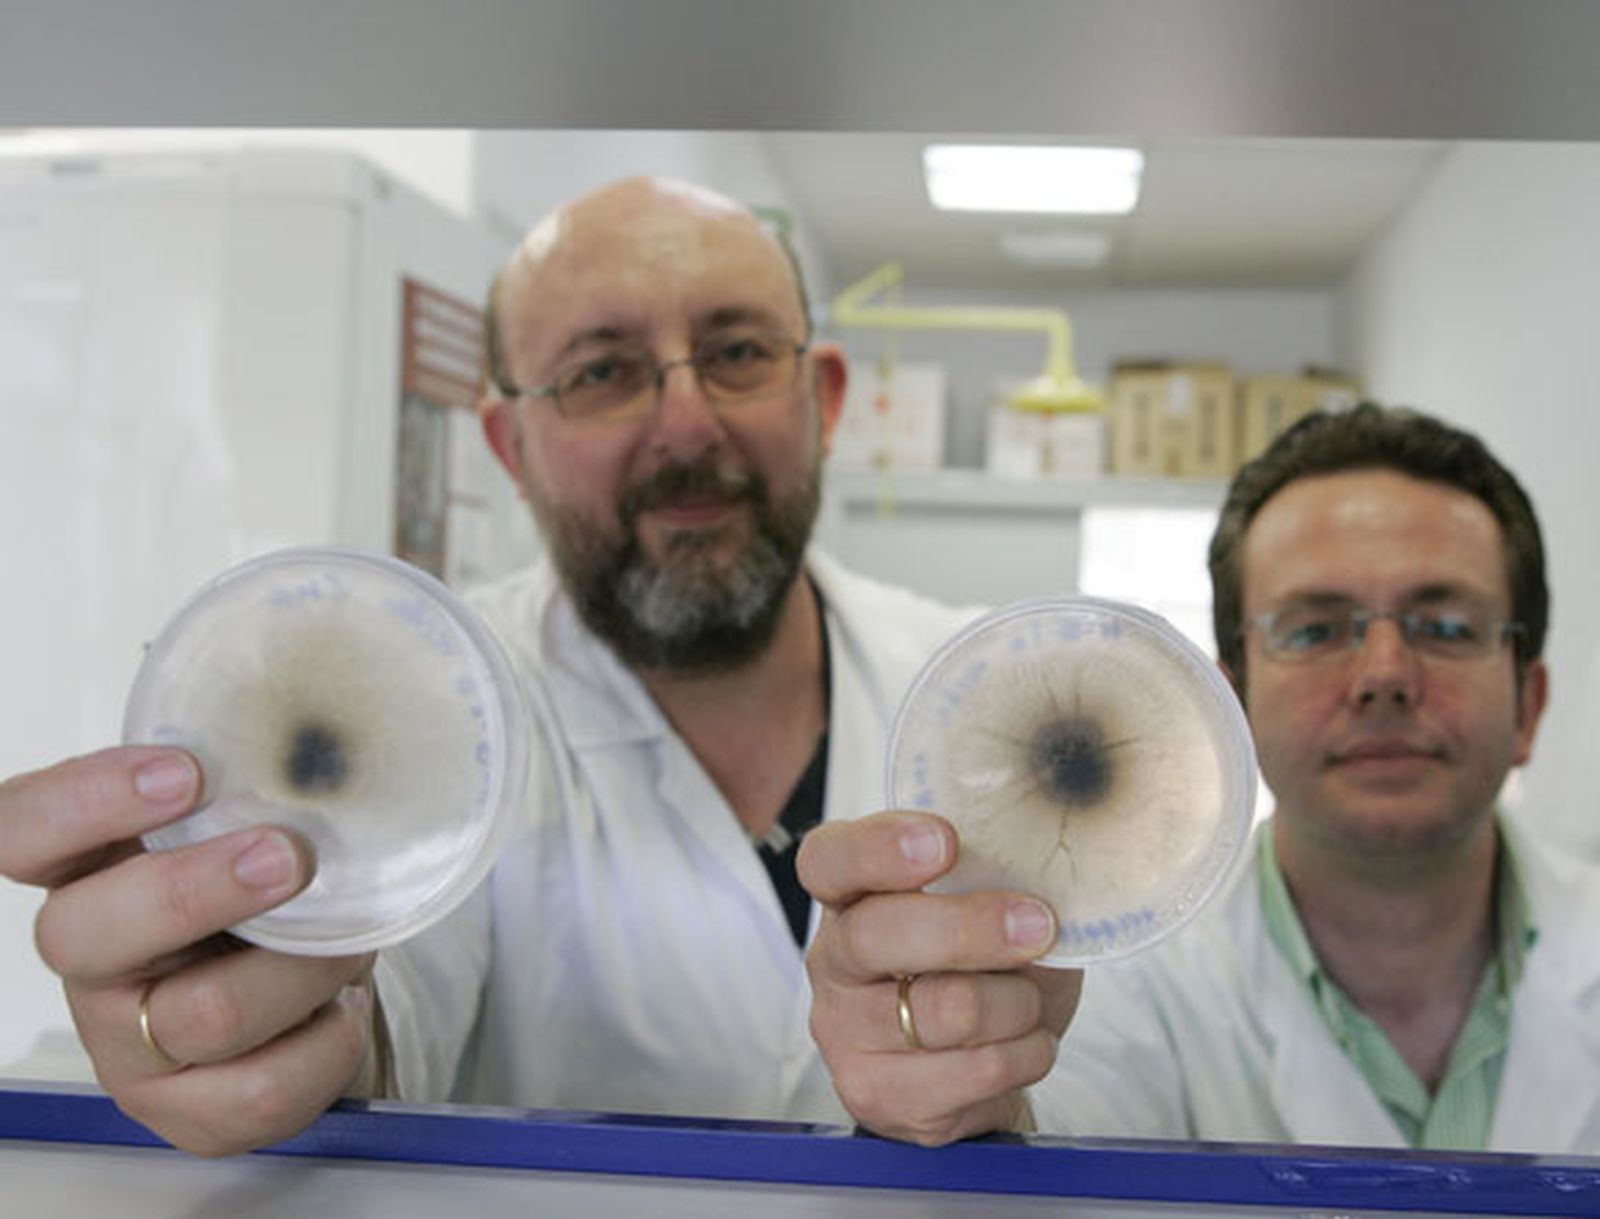

Vino con buena madera
MEDIO AMBIENTE
Científicos de Almería buscan mejorar la calidad de este producto a través del estudio de los hongos presentes en la madera con la que se hacen los toneles

Uno de los factores que más influye en la calidad de cualquier vino es la madera de roble con la que se diseñan los toneles. Antes de servir de recipiente de este producto, ésta debe de pasar por una fase de secado, o curado, que consiste en colocarla a la intemperie durante un periodo que oscila entre uno y tres años y que en España es de dieciocho meses. “Lo que se busca es reducir el exceso de agua para así estabilizar las dimensiones de la madera. Pero no sólo se trata de deshidratar. Esta etapa también es de refinado: la madera verde y agresiva se transforma en seca y aromática”. Así se expresa el investigador de la Universidad de Almería (UAL) José Sánchez, quien, junto a Eduardo Gallego, participa en un proyecto de la Fundación Leia, centro tecnológico con sede en Álava que promueve la mejora ambiental y la transformación tecnológica de las empresas. La investigación, pionera en España, está destinada a mejorar la calidad de la madera en el proceso de secado y, por ende, las propiedades del vino.
En concreto, los profesores de la UAL se están centrando en el estudio de la microbiótica. Se trata de analizar qué hongos están implicados en el secado de la madera de roble, bajo qué condiciones lo hacen y qué compuestos producen. Así se podrá establecer cuál es el impacto de estos organismos en la evolución de la madera. Hasta ahora, sólo dos grupos franceses han trabajado sobre este tema, en tonelerías de Burdeos, y “han señalado la actividad fúngica como uno de los principales parámetros que influyen en este aspecto”. Ahora se trata de comprobar si “los resultados obtenidos en la región de Burdeos y en madera de roble francés son reflejo de una microflora fúngica específica de este tipo de madera o por el contrario cada tierra y cada clima induce una diversidad de clases y especies de hongos”.
Hasta hace muy poco, el proceso de curado se ha basado en conocimientos empíricos. Es decir, en la simple observación. “El único control que se lleva a cabo es el de la disminución de la humedad. Cuando se alcanzan 12 o 14 grados, la madera pasa al interior de la tonelería, y se procede ya al proceso de fabricación”. Ahora, el grupo almeriense ha iniciado sus experimentos con el roble español, distinto del francés, y lo primero que está haciendo es una taxonomía de las especies, por el método tradicional, a través de la observación empírica, y también por el molecular. “Esta se basa en analizar el ADN para comprobar la certeza de la identificación anteriormente realizada por métodos clásicos”. Esta metodología es novedosa en España y es aplicable a todo tipo de maderas, incluidas las de los árboles y los arbustos vivos. Las técnicas moleculares, por tanto, podrán ser utilizadas en la fruticultura o la silvicultura, además de en otros estudios sobre hongos, biodiversidad fúngica y enfermedades vegetales.
También te puede interesar








